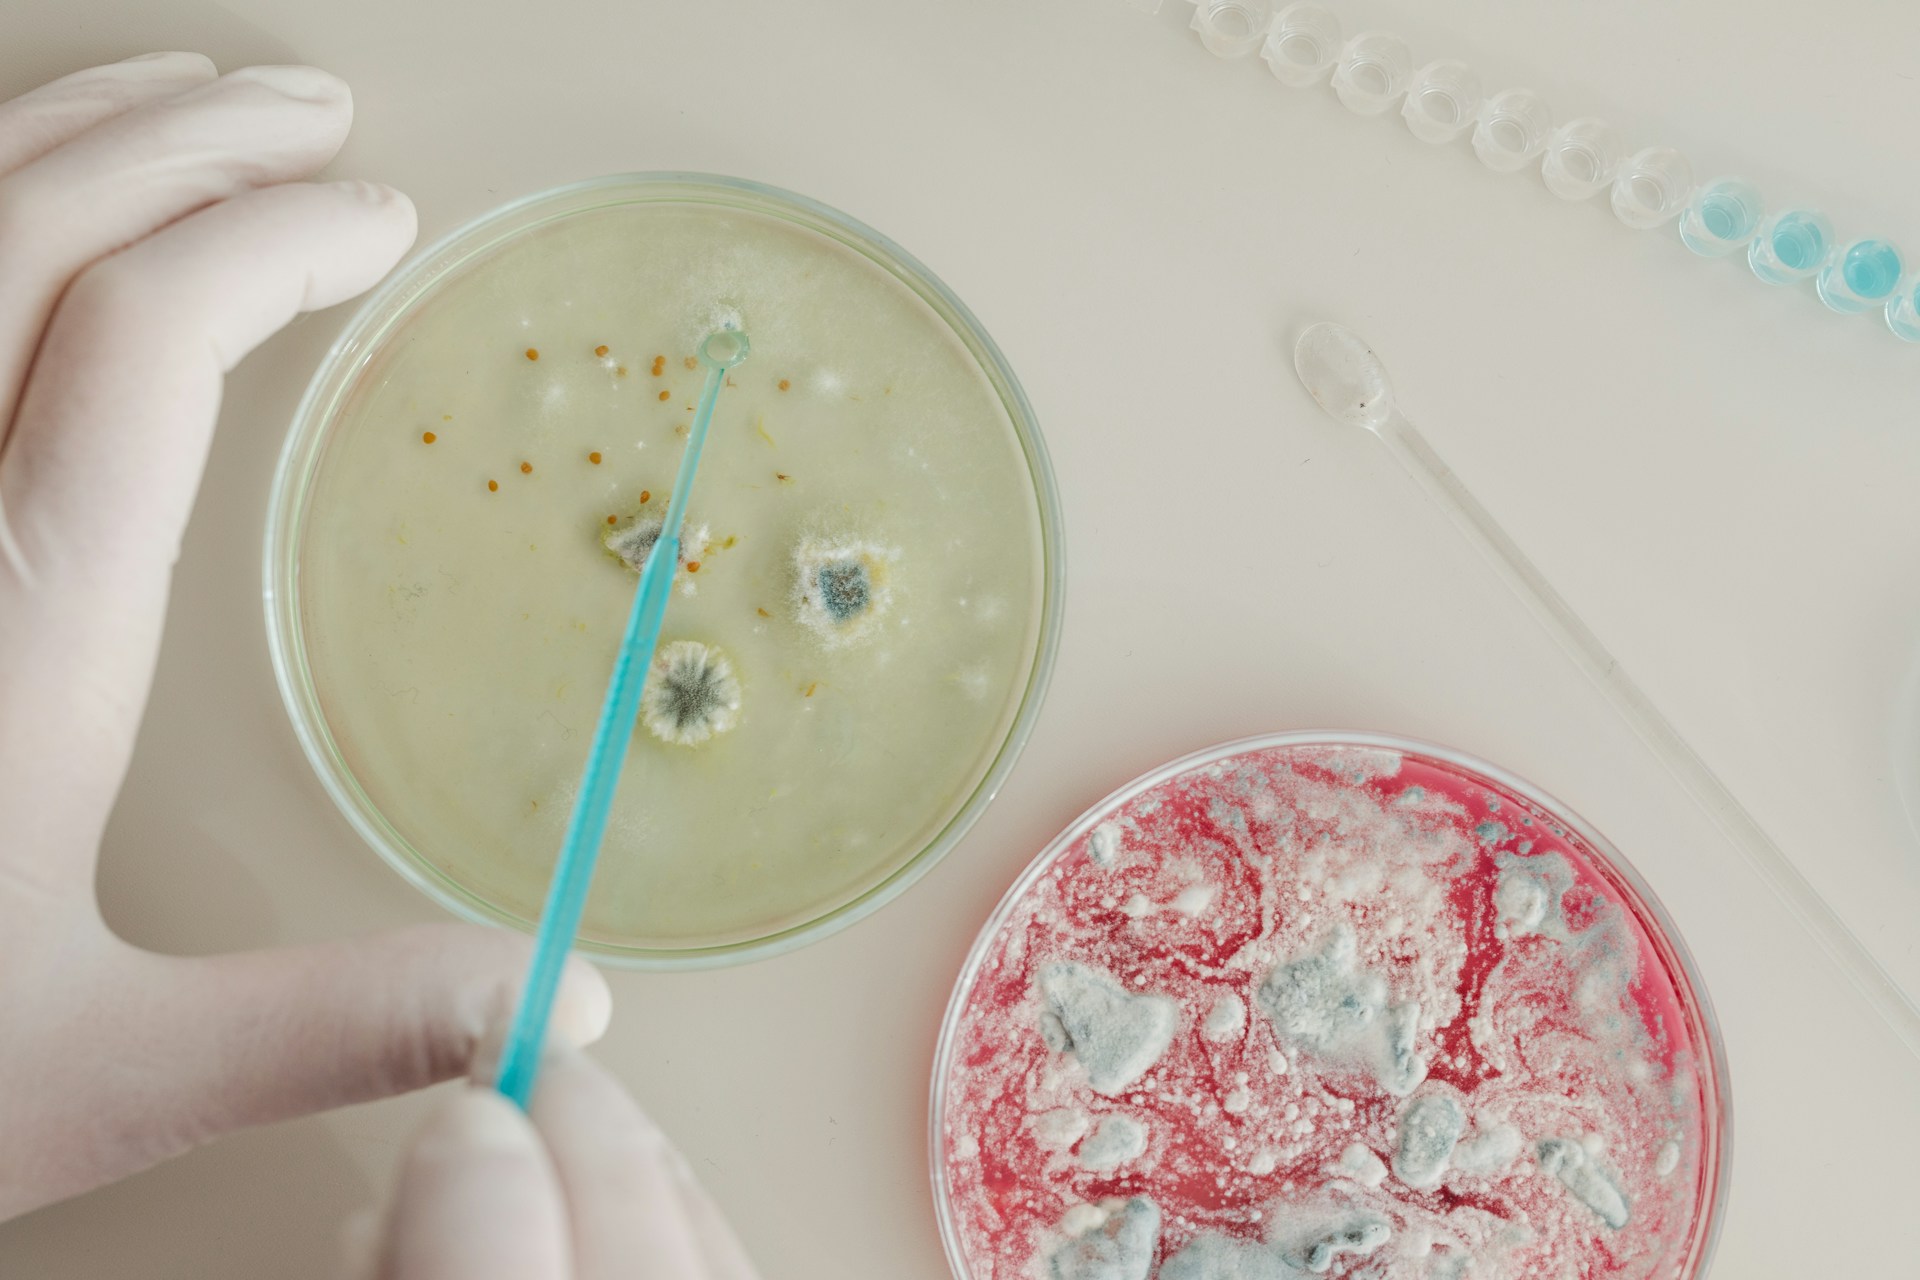
Mold Testing

Night Attic Mold Put My Kids at Risk: How GreenStar HomePro Responded
When a Hidden Threat in Our Attic Turned Life-Threatening Mold in a home is not just an eyesore. It can […]
Night Attic Mold Put My Kids at Risk: How GreenStar HomePro Responded Read Post »